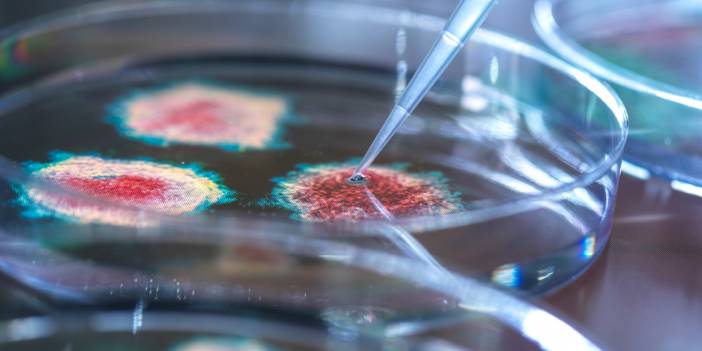
DSÖ'den 'gizemli hepatit' duyurusu: 169 vaka tespit edildi

Gizemli hepatit bu kez Japonya'da

Ulusal basındaki habere göre, Japonya Sağlık Bakanlığından yapılan açıklamada, 16 yaşından küçük bir kişide nedeni bilinmeyen hepatit (karaciğer iltihabı) vakası saptandı. Vaka semptomlarının, Dünya Sağlık Örgütü (DSÖ) bu ay açıkladığı "hepatit virüsü" tanımlamasına uyduğu belirtildi.
Yaşı, adresi ve cinsiyeti bildirilmeyen hastanın karantinaya alındığı kaydedildi.
Sağlık Çalışma ve Refah Bakanı Goto Şigeyuki, ülke genelinde çocuklar arasında vaka artışının kaydedilmediğini söyledi.
"Tek tip semptomlar" bulunmadığı için halka yönelik "spesifik uyarılar" yapamadıklarını belirten Goto, dünya genelindeki benzer vakaları inceleyeceklerini dile getirdi.
Kamu yayıncısı NHK, vakanın, Japonya genelinde ilk olduğunu açıkladı.
Gizemli hepatit vakaları
DSÖ, 16 Nisan'daki yazılı açıklamasında, İngiltere'de 74 çocukta sebebi belirlenemeyen hepatit virüsü tespit edildiğini duyurmuştu. Dün yapılan açıklamada vakaların 11 ülkeye yayıldığı ve en az 169'a yükseldiği belirtilmişti.
Virüsün tespit edildiği çocuklarda son bir aydır sarılık, ishal, kusma ve karın ağrısı gibi belirtilerin görüldüğü, bazı vakaların ise ağır karaciğer iltihabı geçirerek karaciğer nakliyle tedavi edildiği bildirilmişti.
Vakalardan birinin hepatit taşıyan biri veya birkaç kişiyle teması nedeniyle oluştuğu, diğer vakaların virüsü nereden aldığının bilinmediği kaydedilmişti.
Hastalığın "gizemli" veya "nedeni belirsiz" olarak tanımlanması, akıllara Covid-19 virüsünü getirirken yeni bir "küresel salgın" ihtimalini gündeme taşıdı.
Covid-19, henüz adı konulmadan önce "gizemli bir akciğer rahatsızlığı" olarak tanımlanıyordu.
 'Gizemli hepatit' yayılmaya devam ediyor: Yeni küresel salgın mı?
'Gizemli hepatit' yayılmaya devam ediyor: Yeni küresel salgın mı?